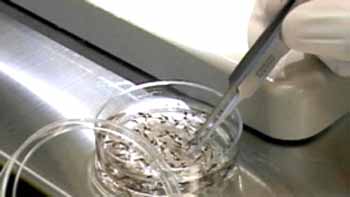

Các nhà khoa học cho biết những tiến bộ trong nghiên cứu y học có thể làm giảm số ca và mức độ trầm trọng của bệnh sốt rét trên toàn thế giới, gần đây Tổ chức Y tế thế giới (WHO) báo cáo về những bước tiến vượt bậc trong cuộc chiến chống lại căn bệnh này.
Ngày Sốt rét thế giới
Nhiều quốc gia đang tổ chức các hoạt động hướng tới ngày Sốt rét thế giới vào thứ Hai, ngày 7 tháng 4 năm nay. Các sự kiện đó nhằm nhắc nhở đến bệnh sốt rét và kêu gọi các nỗ lực phòng chống sốt rét trên quy mô toàn cầu. Theo báo cáo của WHO, có khoảng 207 triệu ca mắc và ước tính 627.000 người chết vì bệnh SR trong năm 2012. Phần lớn các ca tử vong là trẻ em sống ở châu Phi: WHO cho biết cứ mỗi phút có một trẻ em chết vì bệnh sốt rét. Phần lớn các ca sốt rét xảy ra tại các nước châu Phi nằm ở phía nam sa mạc Sahara lớn nhất thế giới. Bệnh sốt rét cũng là một mối đe doạn về sức khỏe cho người dân ở một số khu vực thuộc Châu Á, Trung và Nam Mỹ, Trung Đông và đông nam châu Âu. Khách du lịch từ các quốc gia không có sốt rét đến các khu vực có bệnh lưu hành nặng cũng có nguy mắc sốt rét rất cao. Nguyên nhân là do cơ thể họ có rất ít hoặc không có khả năng đề kháng đối với căn bệnh này. Mầm bệnh gây sốt rét là một loài ký sinh trùng sốt rét được gọi là plasmodium. Muỗinhiễm plasmodium sẽ lan truyền bệnh sốt rét cho con người qua các vết đốt. Ký sinh trùng sau đó phát triển trong gan người, và sau đó ký sinh trong hồng cầu. Sau khi đi vào tế bào máu, chúng lại tiếp tục sinh sôi nảy nở. Quá trình phát triển này đã phá hủy các tế bào máu. Các dấu hiệu của sốt rét xuất hiện trên người bệnh sau khi bị muỗi đốt từ 10 – 15 ngày. Bệnh nhân sẽ bị sốt cao, mệt mỏi, nôn mửa dữ dội, đau đầu và các cơ. Nếu không được chữa trị, sốt rét có thể ảnh hưởng lớn đến sức khỏe người bệnh và thậm chí gây nên tử vong. Ký sinh trùng sốt rét P. falciparum là nguyên nhân chính của hầu hết các ca mắc sốt rét. Tuy nhiên, các chuyên gia khuyến cáo về loài KSTSR ít phổ biến hơn có thể trở thành mối đe dọa nghiêm trọng trong tương lai. Họ đang chứng kiến sự gia tăng của các ca sốt rét do P. vivax.
Ước tính có khoảng 2,5 tỷ người sống trong các khu vực có P. vivax lưu hành. Cho tới gần đây, các chuyên gia tin rằng 95% trong nhóm dân số có nguy cơ cao ở một số khu vực đã được bảo vệ khỏi sốt rét do P. vivax. Nguyên nhân là do họ thiếu một loại protein trong hồng cầu có tên là “Duffy”. Khi không có protein này, P. vivax sẽ không thể xâm nhập vào tế bào máu. Nhưng các nhà nghiên cứu đã tìm ra rằng ở Madagascar, những người không có protein Duffy vẫn có nhiễm ký sinh trùng P.vivax. Họ tin rằng loài ký sinh trùng này có thể đã thay đổi để vượt qua cơ chế kháng tự nhiên để xâm nhập vào các tế bào máu thiếu protein Duffy.
|
Plasmodiumvivax |
Thành công trong cuộc chiến chống lại bệnh sốt rét toàn cầu
Các nhà nghiên cứu vẫn còn lo lắng về số lượng ngày càng tăng các ca sốt rét do P.vivax. Tuy nhiên nỗ lực toàn cầu chống lại sốt rét đang có dấu hiệu khả quan. WHO gần đây đã báo cáo rằng hàng triệu người đã được chữa khỏi bệnh từ năm 2000 bằng các biện pháp phòng ngừa và điều trị tốt hơn; và các chuyên gia y tế mong đợi nhiều thành công hơn nữa khi các chính phủ và các tổ chức tư nhân đang hướng mục tiêu đến các nước châu Phi như Kê-ni-a
 |
| Một người mẹ nhẹ nhàng đặt đứa con trai của mình vào giỏ để đưa đến phòng khám sau khi cậu bé bị nhiễm sốt rét tại Lankien, Nam Xu-đăng |
Báo cáo mới nhất của WHO về tình hình sốt rét cho biết có khoản ba triệu người-phần lớn là trẻ em-đã được cứu sống; và tỷ lệ bệnh nhân tử vong do sốt rét đã giảm xuống đi gần một nửa. TS. Robert Newman chỉ đạo chương trình sốt rét toàn cầu của WHO, cho hay: “Trong hơn 12 năm qua đã có sự gia tăng đáng kể trong các hoạt động tài trợ về tài chính cho các nỗ lực phòng chống sốt rét, và số kinh phí đó được dùng để mua các vật dụng cứu mạng như màn tẩm hóa chất tồn lưu dài, hóa chất phun trong nhà, các bộ thử nghiệm trong chẩn đoán – đặc biệt test chẩn đoán nhanh – và các loại thuốc điều trị sốt rét.” Sốt rét là một vấn đề nghiêm trọng trên hơn 100 quốc gia. TS. Newman dự đoán số lượng tử vong do sốt rét sẽ giảm xuống thậm chí nhiều hơn nữa trong vòng 10 năm tiếp theo: ““Tôi nghĩ rằng chúng ta sẽ chứng kiến nhiều thành công vượt bậc hơn nữa, đặc biệt khi việc đầu tư cho y tế công cộng được chứng minh mang lại hiệu quả hết sức to lớn đến ngày hôm nay, và sẽ có thêm hàng chục triệu người có thể được cứu sống trong 10 năm tới.” Ông cũng dự đoán trong vòng 20 năm nữa sẽ có vắc-xin phòng bệnh SR và lúc đó sẽ góp phần giảm 75% số ca mắc SR. Các chuyên gia cho biết rằng nếu không còn sốt rét, giá trị sản xuất sẽ gia tăng. Người ta sẽ đảm bảo nhu cầu thực phẩm cho gia đình, và họ sẽ dùng tiền để chi tiêu vào việc khác thay vì phải mua thuốc chống sốt rét. Lúc đó, các quốc gia có thể tập trung hơn nữa vào các vấn đề sức khỏe khác ngoài bệnh sốt rét. TS. Joy Phumaphi, hiện làm việc với Liên Minh Sốt Rét Các Nhà Lãnh Đạo Châu Phi, cho biết: “Một khi không còn trẻ em mắc sốt rét vốn chiếm phần đông trong các khoa nhi của bệnh viện như hiện đang diễn ra tại nhiều nước có bệnh SR lưu hành, chúng ta sẽ sử dụng rất nhiều nguồn lực để tập trung chống lại các căn bệnh khác hiện đang là gánh nặng của cộng đồng”.
Phòng chống sốt rét
Việc gia tăng hiện tượng kháng các loại thuốc chống sốt rét và các sản phẩm diệt côn trùng cũng là một trong những vấn đề cần giải quyết trong cuộc chiến chống lại bệnh sốt rét. Thế nhưng TS. Newman cho biết thậm chí còn có một mối đe dọa lớn hơn nữa: “Mối đe dọa nghiêm trọng nhất đối với việc phòng chống và loại trừ hoàn toàn bệnh sốt rét đó là vấn đề tài chính.” Biện pháp chính trong phòng chống sốt rét bao gồm xử lý màn ngủ và các khu vực sinh hoạt trong nhà bằng hóa chất diệt muỗi. Tổ Chức Y Tế Thế Giới (WHO) cho biết hóa chất diệt côn trùng có giúp giảm thiểu các ca mắc sốt rét. WHO cho biết màn tẩm hóa chất đã được chứng minh là giảm số ca sốt rét tới 50% và tỷ lệ nhiễm đến 90%.
 |
| Hai mẹ con đang ngồi trên giường có mắc màn chống SR gần Bagamoyo, cách thủ đô Dar es Salaam của Tanzania 70 km về phía bắc |
“Đây là một câu chuyện cổ tích không có hồi kết, kể về một nàng công chúa cần phải đấu tranh để bảo vệ mình…”. Gần đây, Quỹ Phòng chống Sốt Rét đã làm việc với một nhóm sinh viên xây dựng một đoạn phim ngắn về những mối nguy hiểm của sốt rét. Ngôi sao điện ảnh Susan Saradon tỏ vẻ thích thú với sản phẩm của họa. Cô tình nguyện trở thành diễn giả cho dự án này. “Quỷ Vương Sốt Rét đã hút no máu. Ký sinh trùng trong người hắn bắt đầu lan truyền bệnh. Qua tế bào máu vào gan. Máu của công chúa trở thành một dòng sông đầy chết chóc. Trong video, xuất hiện một cô bé đang nằm ngủ. Bạn sẽ nghĩ cô ấy có thể có một giấc mơ yên bình của một đứa bé. Nhưng thay vào đó, một con muỗi lớn tấn công cô, và cô bị nhiễm bệnh sốt rét. “Cơn ác mộng này là một mối đe dọa toàn cầu, tuy nhiên thứ đơn giản nhất có thể ngăn chặn nó - đó là một cái màn. Nó chỉ là một đồ vật đơn giản dễ mua, và vì có nó hàng triệu người như cô công chúa kia sẽ không chết.” Đó chính là vai công chúa của nữ diễn viên Susan Sanradon trong “Ác mộng”, một video ngắn cảnh báo về nguy hiểm của sốt rét”.
Quỹ Nhi Đồng Liên Hợp Quốc và các tổ chức khác đã cung cấp màn ngủ cho các khu vực bị ảnh hưởng bởi bệnh SR. Nhưng theo các cơ quan này, nguồn ngân sách chỉ đáp ứng một nữa so với nhu cầu phòng chống và điều trị bệnh SR, và họ khuyến cáo rằng nếu không có thêm những hỗ trợ tài chính nữa, sẽ mất đi những thành tựu phòng chống SR đã đạt được. Việc phát hiện sớm và điều trị bằng thuốc có thể làm giảm sự nguy hiểm của bệnh sốt rét và ngăn ngừa tử vong. Thuốc sốt rét chloroquine đã được sử dụng rộng rãi cho đến những năm gần đây khi ký sinh trùng sốt rét đã kháng lại thuốc này. Hiện nay, WHO khuyến cáo sử dụng thuốc phối hợp chứa gốc artemisinine, hoặc ACTs cho các bệnh nhân sốt rét. WHO cho biết cộng đồng quốc tế đang trong tình thế sẵn sàng đánh bại sốt rét. WHO cho biết rằng, cùng với việc sử dụng hóa chất diệt muỗi, phương pháp chẩn đoán và điều trị được cải thiện, thế giới có thể đạt được mục tiêu không còn bệnh nhân tử vong do sốt rét trước năm 2015.